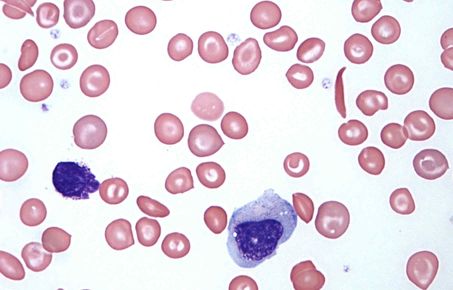

Our work
Imperial College conducts integrated programmes encompassing all aspects human health at the interface of humans and environment that have made major contributions to regional and global health, in particular, the translation of research into policy and practice. These web pages highlight the scope and diversity of our work and engagement and aim to be updated continuously with our recent outputs.